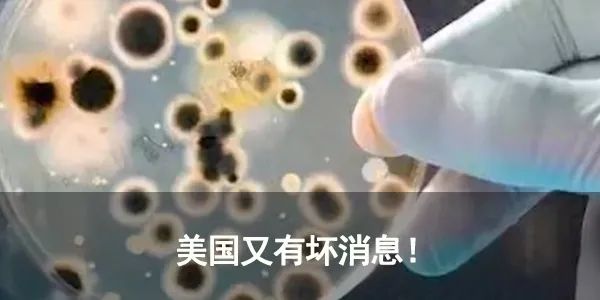

在手机继续浏览本文,也可以分享给你的联系人。
中国搜索
颁布施行多年的国旗法、国徽法迎来重要修改。8月8日,国旗法修正草案和国徽法修正草案提请十三届全国人大常委会第二十一次会议审议,涉及增加升挂国旗、悬挂国徽的场合,规范国旗、国徽的使用,强化国旗宣传教育等多个方面,国家标志制度有望进一步完善。
看点一:增加升挂国旗、悬挂国徽的场合
两个修正草案在升挂国旗和悬挂国徽的时间、场合方面作出修改完善。
比如,在现有规定基础上,为体现中国gongchandang在国家中的领导地位,增加规定,“中国gongchandang中央委员会”每日升挂国旗,“中国gongchandang中央各部门和地方各级委员会”在工作日升挂国旗。为体现国家监察体制改革后国家机构新变化,增加规定,“中国gongchandang中央纪律检查委员会、国家监察委员会”每日升挂国旗,“中国gongchandang地方各级纪律检查委员会、地方各级监察委员会”在工作日升挂国旗;明确各级监察委员会悬挂国徽。增加各民主党派、各人民团体在工作日升挂国旗的规定。增加非全日制学校和公共文化设施升挂国旗的规定。增加规定宪法宣誓场所悬挂国旗、国徽等。
中国法学会宪法学研究会常务副会长莫纪宏认为,现行国旗法、国徽法对升挂国旗和悬挂国徽的时间、场合规定较为笼统,修正草案对此作出进一步细化,强化了升挂国旗和悬挂国徽的权威性和严肃性。两个修正草案明确相关规范,有助于强化相关部门和单位升挂国旗和悬挂国徽的法律意识。

看点二:严禁损害国旗、国徽尊严等行为
两个修正草案的又一重要修改,是对损害国旗、国徽尊严的行为作出禁止性规定。
比如,国旗法修正草案明确,不得倒挂或者以其他有损国旗尊严的方式升挂、使用国旗;不得随意丢弃国旗;大型群众性活动结束后,活动主办方应当妥善处置活动现场使用的各类国旗。修正草案还强调,公民和组织在网络中使用国旗图案,应当遵守相关网络管理规定,不得损害国旗尊严。
根据两个修正草案,在公共场合故意以焚烧、毁损、涂划、玷污、践踏等方式侮辱国旗、国徽的,依法追究刑事责任;情节较轻的,由公安机关处以十五日以下拘留。
上海交通大学学生马文斌说,如果这些修改通过,今后看到一些损害国旗、国徽尊严的行为,也更有底气去及时制止了。
看点三:规范升旗仪式要求
国旗法修正草案对升国旗仪式的要求作出修改:举行升旗仪式时,应当奏唱国歌,在国旗升起的过程中,参加者应当面向国旗肃立行注目礼或者按照规定要求敬礼,不得有损害国旗尊严的行为。草案还增加规定,北京天安门广场每日举行升旗仪式,由中国人民解放军仪仗队负责。
中国法学会宪法学研究会秘书长张翔表示,这些修改进一步明确了升国旗仪式参加者的礼仪规范,将增强升国旗仪式的庄严感和仪式感。同时,北京天安门广场的升国旗仪式,已经在长期的实践中成为公众瞩目和参与度非常高的日常仪典。修正草案通过法律形式对这项仪式予以明确,是适应实践发展的需要。
国旗法修正草案还规定,国家鼓励图书馆、博物馆、文化馆、美术馆、科技馆、纪念馆、青少年宫等公共文化设施在开放日升挂国旗。上海市浦东新区图书馆副馆长施丽表示,该规定能唤起公民内心真挚朴素的爱国情感,对这样的修改非常赞同。
看点四:明确监督管理部门
现行法律没有明确国旗、国徽的具体监管部门,在实践中导致监管不到位。两个修正草案对此增加规定,由国务院确定的部门统筹协调全国范围内国旗、国徽管理有关工作,地方各级人民政府统筹协调本行政区域内国旗、国徽管理有关工作。地方各级人民政府市场监督管理部门对本行政区域内国旗、国徽的制作和销售,实施监督管理;县级人民政府确定的部门对本行政区域内国旗、国徽的升挂(悬挂)、使用和回收,实施监督管理。
张翔表示,此次两个修正草案的一大亮点,就是明确了国旗、国徽监督管理主体,规定了国旗、国徽制作、销售、升挂、使用、回收等方面监管责任,让监管工作的开展更加有法可依。
莫纪宏说,上述修改有利于进一步强化各级人民政府和部门在保证国旗法、国徽法实施中的法律职责,加强对国旗、国徽的管理,并建立责任机制。
看点五:加强国旗宣传教育
“国家倡导公民和组织在适宜的场合使用国旗及其图案,表达爱国情感。”国旗法修正草案的多处规定,体现出加强国旗宣传教育的鲜明导向。
比如,规定全日制学校应当将国旗教育作为爱国主义教育的重要内容,教育学生了解国旗的历史和精神内涵,遵守国旗升挂使用规范和升国旗仪式礼仪;增加国家宪法日、烈士纪念日等重要纪念日升挂国旗的要求,对居民小区等在重要节日、纪念日升挂国旗作出规定。
上海市闵行区中心小学校长金建芳表示,这些修改从法律层面上为学校开展爱国主义教育提供了支持和保障。
“修正草案让我们在开展国旗教育方面有了更明确的目标。一方面,我们要通过课堂主渠道强化国旗教育;另一方面,要从校园文化环境氛围上着手,以重大节庆日、纪念日为契机开展国旗教育。”金建芳说。
特别推荐

来源:新华视点
编辑:何 艳
校对:苏 文
监制:郎荐辕